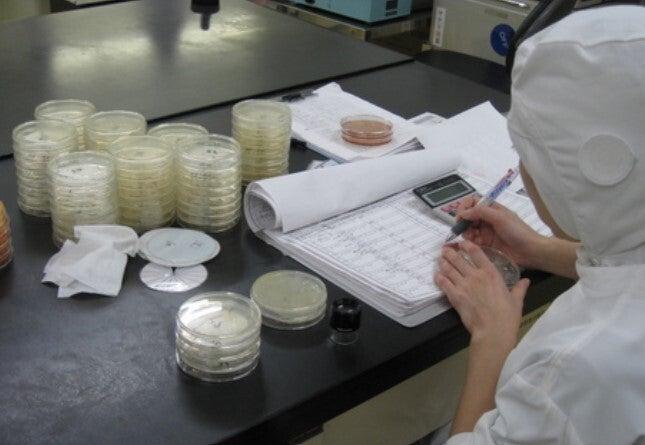
株式会社デリカシェフ　久喜工場の仕事画像3

勤務地
- [最寄駅]
- 埼玉県久喜市 ⁄ 久喜駅 (車 13分) ほか
- [住所]
- 埼玉県久喜市清久町49-2
- 無料送迎バス乗り場↓
〒346-0003 埼玉県久喜市久喜中央1丁目5
- 埼玉県久喜市清久町49-2
地図・アクセス詳細を見る
勤務日数
週2・3〜OK、週4〜OK
勤務時間
- ア・パ08:50~16:50
※休憩1時間あり
■週3日から勤務OK
■1か月の勤務が12~13日のシフト制です!
※年中無休の工場です。
土日の半分程度は出勤をお願いしています。
■入社半年後に有給付与
勤務時間、シフト等でご希望があれば
お気軽にご相談ください♪
小さなお子さんがいる方など短時間勤務も相談可。
休日・休暇
交代制
シフトはご相談ください。
職種
株式会社デリカシェフ久喜工場
- ア・パ検査
給与
- ア・パ時給1,141円~
交通費:全額支給
車・バイク・自転車通勤OK!
無料駐車場完備、ガソリン支給。
久喜駅から無用送迎バスもあります♪
時給変動等などもありません!
もちろん扶養内勤務もOKです!
■昇給あり
■労災・雇用・健康・厚年保険制度あり
■特別社内販売あり
子育てと両立している主婦(夫)さんも
多数活躍中です。
髪色も自由♪
試用期間:なし
勤務期間
長期
お気軽にご相談下さい!